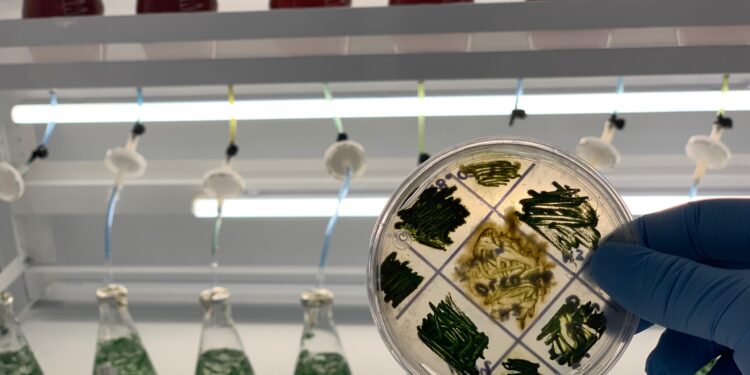

Microalgas Oleas de México colecta, purifica y cultiva cianobacterias y microalgas, endémicas de México para desarrollar y comercializar bioestimulantes agrícolas que llevan al cultivo a su máxima potencia genética.
Por Ana Isabel Rodríguez*
Jalisco, México. – Poca gente lo sabe, pero las microalgas son las responsables del 80 por ciento del oxígeno que respiramos. Por lo general, tenemos la idea de que las principales fuentes de oxígeno son los árboles y las plantas, pero quienes realizan el mayor esfuerzo para generar este elemento vital son las microalgas, dispersas en cuerpos de agua, explica Elsa Aydé Guzmán Hernández, jefa comercial de Microalgas Oleas de México.
Al ser “limpiadoras del aire”, tienen una huella negativa de carbono; es decir, en lugar de emitir dióxido de carbono, emiten oxígeno. Respiran dióxido y exhalan oxígeno, explica la especialista en entrevista para Agro Orgánico.
Con base en los beneficios y el potencial de las microalgas, esta empresa –100 por ciento mexicana– colecta, purifica y cultiva masivamente diversas especies de microorganismos, principalmente cianobacterias y microalgas, endémicas de México.
Esto les ha permitido desarrollar y comercializar bioestimulantes agrícolas que llevan al cultivo a su máxima potencia genética. “Si genéticamente una planta de tomate, por ejemplo, está destinada a producir 100 kilos en un ciclo, no puedo prometer que la producción será mayor, pero sí que el cultivo alcanzará su máximo potencial para obtener los rendimientos esperados”, apunta Elsa Guzmán.
Otro beneficio de los bioestimulantes de microalgas es que disminuyen las aplicaciones de fertilizante y agua, ya que permiten que las plantas asimilen de forma óptima los nutrientes disponibles. Uno de estos productos es Ficocyan Filler, un bioestimulante orgánico de alga espirulina enriquecido con potasio y boro que beneficia la división celular, la polinización y el desarrollo de frutos.
Es importante destacar que la materia prima –la microalga espirulina– es producida por Microalgas Oleas en su propia planta donde están los biorreactores que permiten cultivar y cosechar una cepa regional del Lago de Texcoco.
La espirulina, considerada un “súperalimento” por los beneficios nutricionales para consumo humano, también alimenta a los cultivos, apunta Elsa Guzmán, y agrega que un factor diferenciador de su tecnología es que saben cómo crecen las algas, qué comen y qué porcentajes contienen de proteínas, carbohidratos, lípidos, sales, entre otros elementos.
La espirulina –explica– contiene entre 60 y 70% de proteína. Microalgas Oleas realiza un proceso de hidrólisis enzimática que permite liberar los aminoácidos, que son la principal herramienta para prevenir y corregir el estrés en los cultivos.
Esta microalga contiene aminoácidos, D – aminoácidos y L – aminoácidos, siendo estos los que más ayudan a las plantas, al permitirles una bioasimilación instantánea que les facilita la absorción sin necesidad de que metabolice ninguna sustancia.
Esto es posible porque en la hidrólisis, los polifenoles, polisacáridos, sales y aminoácidos se procesan de una forma bioasimilable y biocompatible para que la planta absorba las sustancias rápidamente.
Además, al acelerar la actividad metabólica de las plantas, los bioestimulantes de microalgas son también inductores de floración. Esto permite tener precocidad en las cosechas, que se traduce en mejores ingresos para el productor.
Por otra parte, los suelos también se benefician con la aplicación de estos productos que, al ser orgánicos, no tienen residualidad negativa. Todo lo que la planta no consuma –comenta la directora comercial de Microalgas Oleas– se queda en el suelo y servirá como nutriente para los microorganismos.
Otro producto de la misma línea, Ficocyan Nostoc es un bioinoculante elaborado con cianobacterias de agua dulce o terrestre, de color verde azulada. Considerado un biofertilizante, este producto permite fijar nitrógeno atmosférico, lo que reduce los niveles de fertilización y de aplicación de agua, porque también retiene la humedad.
Las cianobacterias –menciona Elsa Guzmán– entran en simbiosis con los microorganismos que habitan en el suelo. “Las micorrizas, trichodermas y otras bacterias benéficas, entran en esta simbiosis en la que todos los microorganismos conviven y proliferan por esta interacción”.
Estos beneficios han sido comprobados por clientes de Microalgas Oleas dedicados al cultivo de berries, agaves, pimientos, chiles, ajo, entre otros cultivos, aunque también han dado muy buenos resultados en cítricos, granos y leguminosas.
Lee la entrevista completa y descarga la edición digital totalmente gratis en: https://agroorganico.info/wp-content/uploads/2022/11/35_Agro_Organico.pdf
*Directora editorial de Agro Orgánico